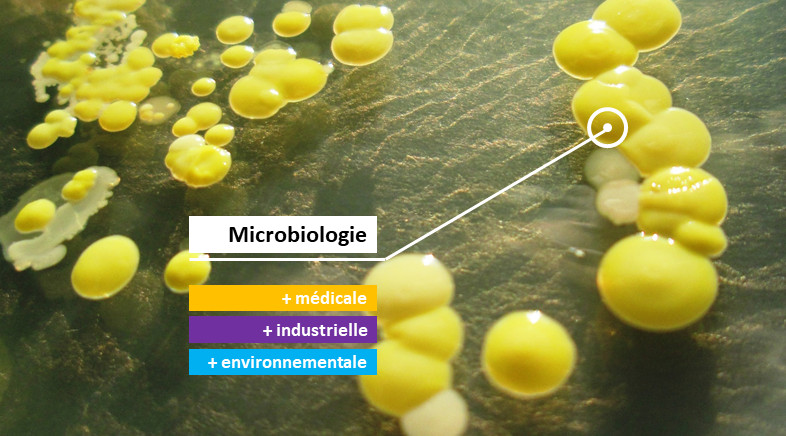

Collègue, étudiant, élève ou simple visiteur, bienvenue sur le site de l'association nationale des professeurs de biotechnologies !
Photos : (1), (2) et (3) © Antoine GAUDIN pour UPBM ; (4) © Nicolas RAVELLI pour UPBM ; slideshow © Antoine GAUDIN et Cédric CIVEL pour UPBM.